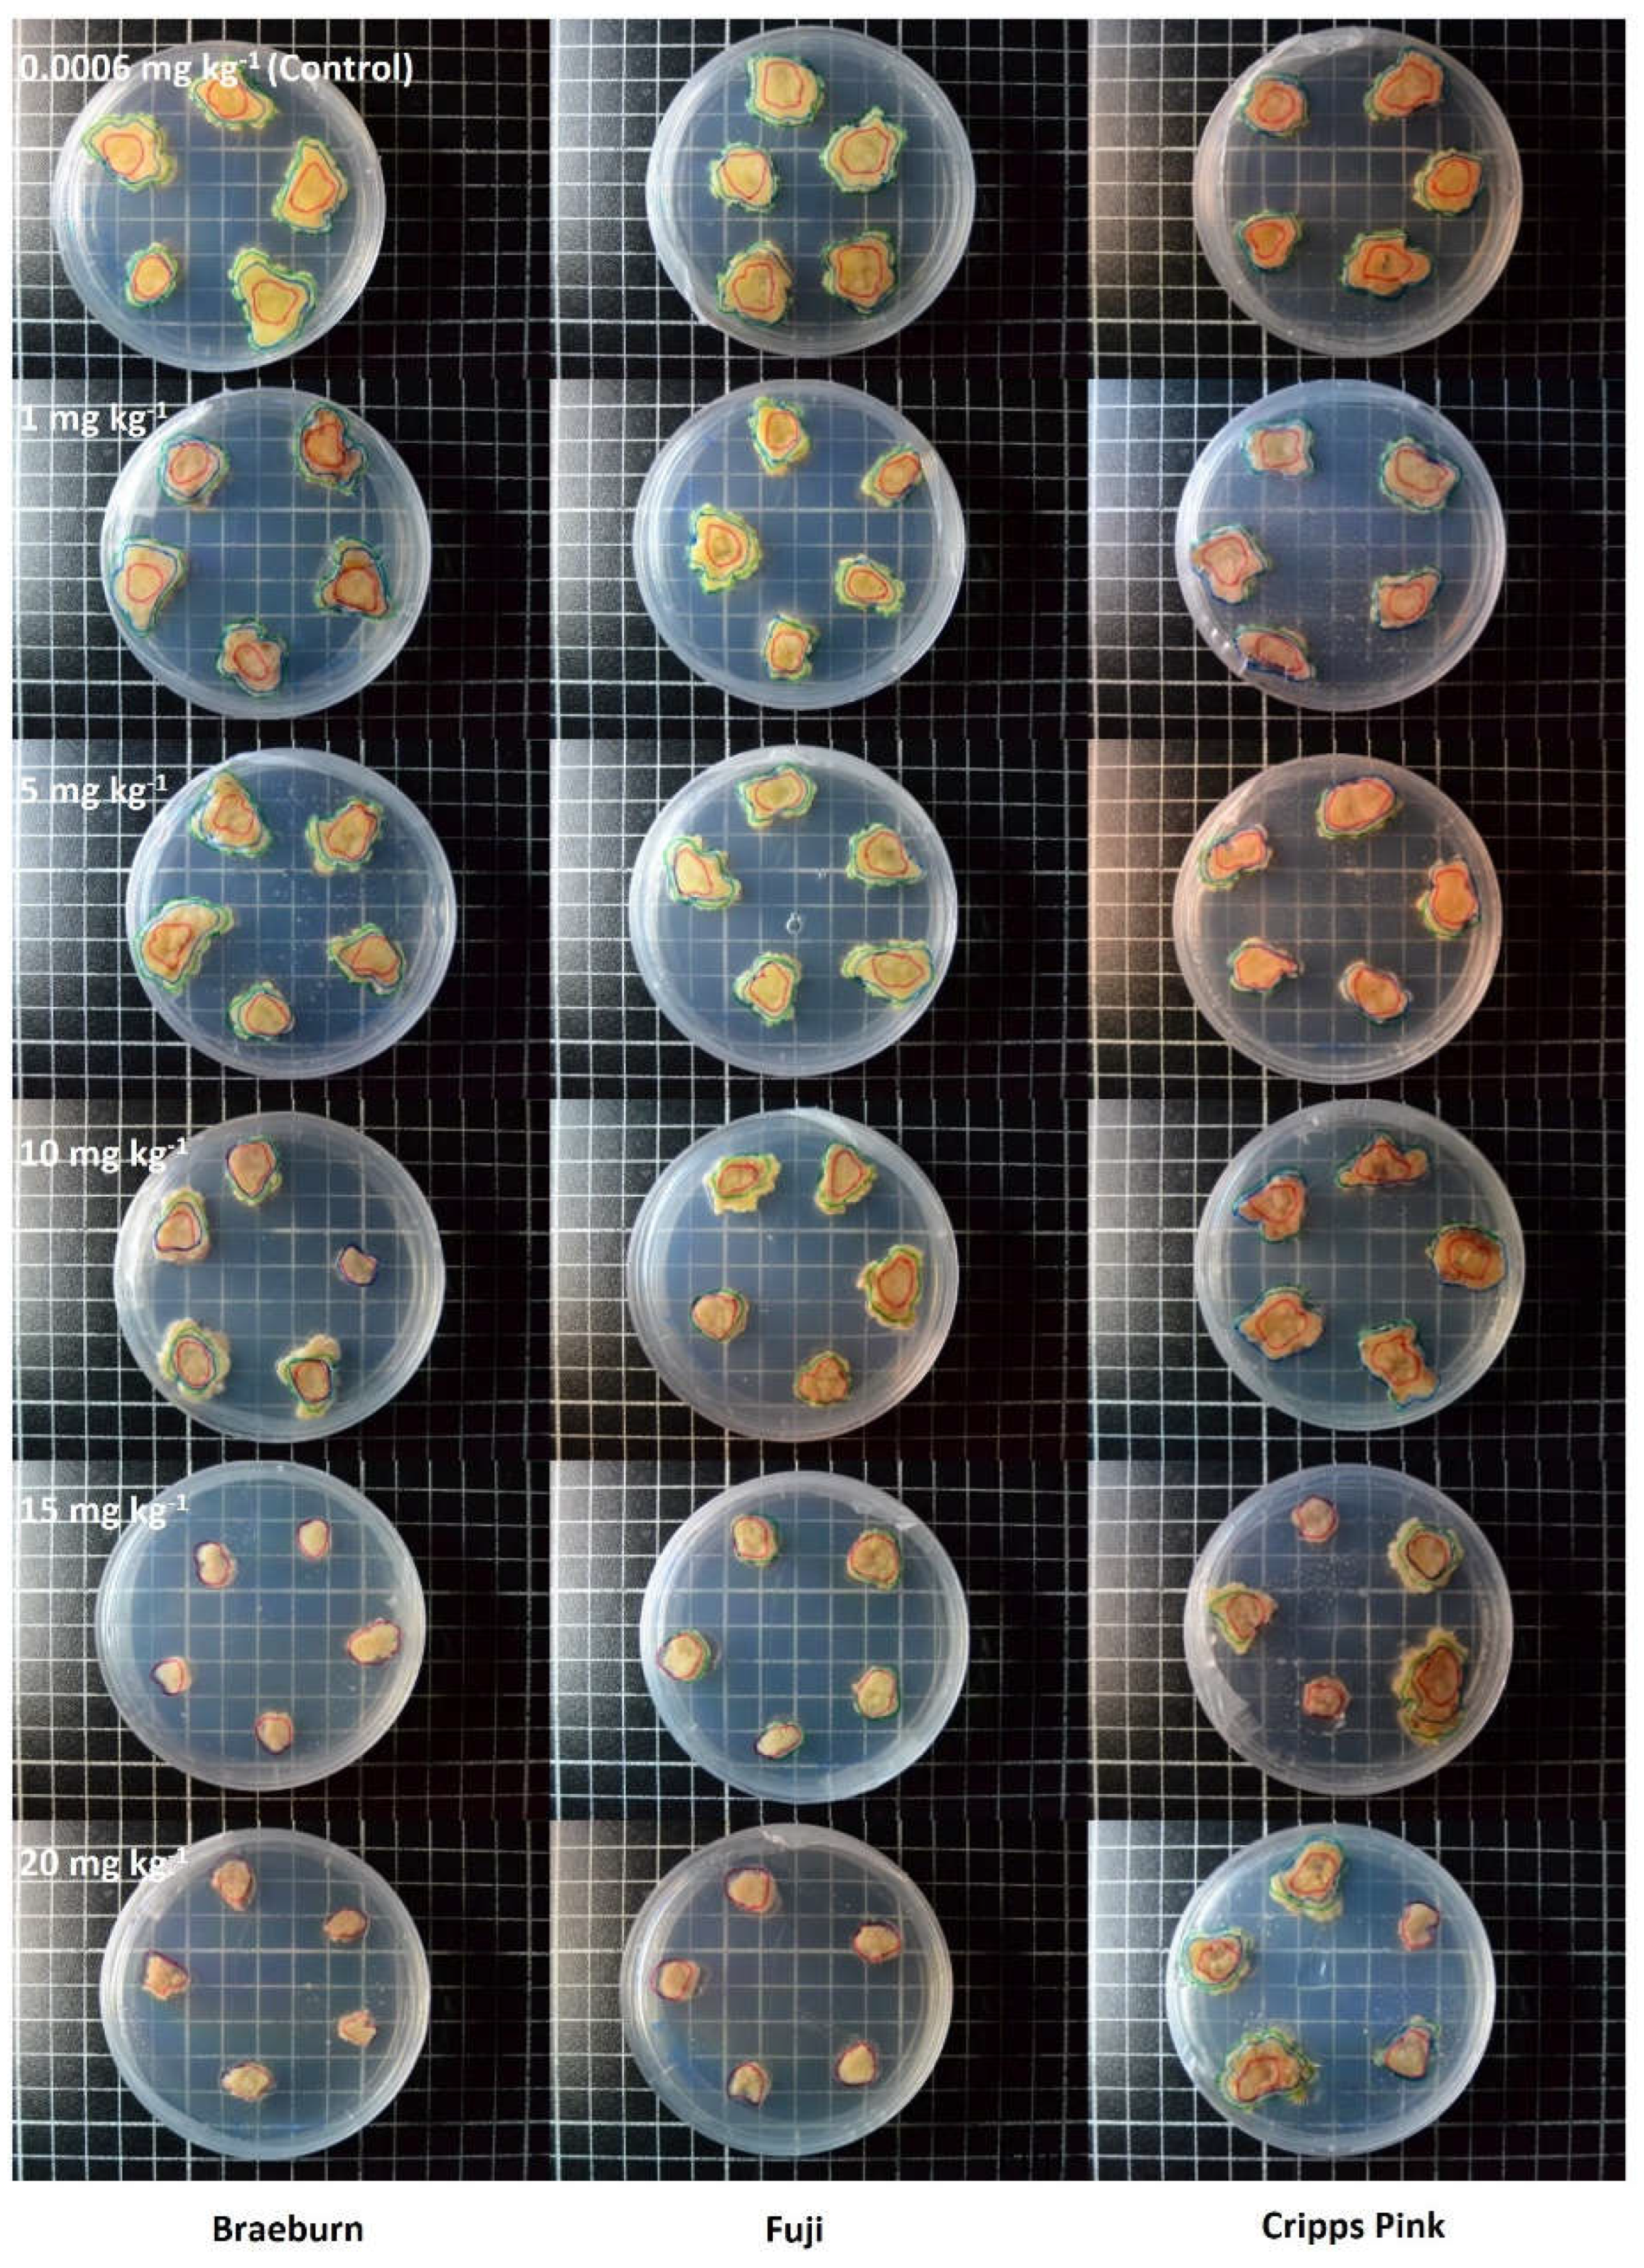
Preprints 118810 g002

1. Introduction
Apples accounted for over 40 % of fresh fruit in horticultural exports in New Zealand in 2020 (Freshfacts, 2020). New Zealand exports approximately 360,000 metric tons of apples to 80 countries (Statistics NZ, 2021). Apple export has increased gradually since 1989, and a healthy apple orchard environment is undoubtedly crucial to the economy. Among apple varieties, the Royal Gala (33 %) is New Zealand’s largest volume variety, followed by Braeburn (12 %), Jazz (9 %), Fuji (8 %) and Cripps Pink (7 %) (Freshfacts, 2020). Three apple varieties were selected in the present study.
Long-term use of Cu-based fungicides increases Cu accumulation in orchard soils (Girotto et al., 2014; Komárek et al., 2010b; Liu et al., 2011). Cu concentration in apple orchard soils in China has been shown to have increased substantially due to the application of Cu, more than 16 kg ha−1 Cu per year, ranging from 2.5 to 9 mg Cu kg−1 (Li et al., 2005). The present study recorded the total Cu concentration in the soil in two apple orchards in New Zealand as > 60 mg Cu kg-1.
The use of Cu-based fungicides for disease control on apples has always been viewed from two directions, as very positive disease-control benefits are counterbalanced by the risk of phytotoxicity to trees and soil and contamination of fruit (Sundin, 2012). Two major apple pathogens, the fire blight pathogen Erwinia amylovora and the apple scab pathogen Venturia inaequalis, are susceptible to Cu (Vanneste, 2000). These two diseases can devastate apple trees (Norelli et al., 2003), so Cu-based fungicides have been used for many years in New Zealand. It has long been established that Cu can be toxic to plants in high concentrations. One of the typical toxicity symptoms of Cu is inter-veinal chlorosis. Excessive amounts of Cu in orchard soils can impair the growth of roots and shoots (Bouazizi et al., 2010), restrain photosystem II activity, inhibit protein synthesis and enzyme activities, reduce carbohydrate concentrations and induce plant senescence and even death, resulting in lower fruit productivity (Brunetto et al., 2016b; Cambrollé et al., 2015; Chatterjee & Chatterjee, 2000; Chen et al., 2018; Hippler et al., 2016; Liu et al., 2011; Wang et al., 2015).
Previous studies have demonstrated that Cu uptake, compartmentalization, and tolerance characteristics are highly variable among plant species and cultivars within the same (Cao et al., 2018; Lange et al., 2018). However, relatively little literature is currently available on Cu accumulation and tolerance in apple trees, and most of them have focused only on rootstocks. Rootstocks of horticultural crops regulate plant growth and development and affect Cu uptake, accumulation and toxicity through ion exclusion or retention (Hippler et al., 2016; Liu et al., 2011). Progress has been made in demonstrating the physiological mechanisms of excess Cu uptake, accumulation and tolerance in grapevine rootstocks (Cambrollé et al., 2015; Marastoni et al., 2019) and citrus (Hippler et al., 2016). Excess Cu suppressed plant biomass and root architecture, less pronounced in Malus prunifolia Borkh. Then other four apple rootstocks (Malus asiatica Nakai., Malus baccata Borkh, Malus hupehensis Rehd. and Malus micromalus Makino) indicating its relatively higher Cu tolerance (Wan et al., 2019). The Cu concentration in the Delicious apple variety’s tissues increased with heavy metals in soil from the polluted area (Imeri et al., 2019).
In-vitro tissue culture provides an important tool to study the physiological and biochemical mechanisms that operate in response to stress at the cellular level. Plant tissue culture allows experimental control of heterogeneity and characterization of cell behavior under stress, independently of regulatory systems that operate at the whole plant level (Errabii et al., 2007). Tissue culture can also be useful to enhance metal tolerance through the in vitro selection of tolerant cell lines that can be regenerated into whole plants. Callus is unorganized cell mass growth, similar to wound-healing plant tissue (Skoog & Miller, 1957). Callus represents a proliferating mass of cells (Fehér, 2019). Callus culture potentially provides a simple way to understand the impacts of forms. The selection and characterization of various cell cultures tolerant to heavy metals have been documented (Gladkov, 2023; Gori et al., 1998).
The aim of the present study was to investigate the effects of varying copper concentrations on the physiological responses of apple varieties using a callus-media system. The objectives were: 1) to assess the influence of varying copper concentrations on the physiological traits of three apple varieties using a callus-media system, 2) to determine the threshold at which copper concentrations begin to override varietal differences in physiological responses, and 3) to explore how findings from the callus-media system may inform potential impacts on apple performance in soil-plant systems.
2. Materials and Methods
2.1. Plant Materials
Three apple varieties (Braeburn, Fuji and Cripps Pink) were obtained from three apple orchards in Hastings, New Zealand, in November 2022 (
Table 1). Twenty shoot cuttings were randomly sampled in a single block in each orchard and nutrient contents were conducted (
Table 2, triplicates). Specimens were stored for two weeks at the laboratory incubator (5 ± 0.5 °C, 60 % humidity) at Lincoln University until callus induction. Three apple orchards’ soils were analyzed as a background data (
Table 3).
[
1] 1:2 (v/v) soil: water slurry followed by potentiometric determination of pH. [
2] GBC Avanta Atomic Absorption Spectrophotometer (AAS). [
3] Olsen P extraction followed by Molybdenum Blue colourimetric. [
4] 1M Neutral ammonium acetate extraction followed by ICP-OES. [
5] Summation of extractable cations (K, Ca, Mg and Na) and extractable acidity. [
6] CN analyzer. [
7] anaerobic incubation at 40ºC for 7 days. [
8] Loss on Ignition (LOI). [
9] The bulk density of dried, ground soil.
2.2. Sterilisation
Ten young and healthy leaves were thoroughly rinsed under running tap water for 10 mins and then sterilized with 10 % bleach for 30 seconds. Sterilized samples were rinsed three times using deionized water. The samples were placed in 75 % (v/v) ethanol for 30 mins and rinsed three times again using deionized water three times in a laminar flow cabinet. The sterilized leaves were cut into 0.5 cm x 0.5 cm pieces in a laminar flow cabinet to make explants.
2.3. Media Preparation
The culture medium used was MS + vits (Murashige and Skoog + vitamin salts) (Murashige & Skoog, 1962) supplemented with 5 g L−1 agar, 20 g L−1 sucrose, 0.5 % phyto-agar and plant hormones (0.4 mg L−1 BA, 0.1 mg L−1 NAA, TDZ). The pH of the medium was adjusted to 5.8 with 0.1 N HCl or 0.1 N KOH prior to autoclaving (121 °C and 1.06 kg cm−2 pressure for 15 mins). Autoclaved 1L solution mix was poured into 20 plastic Petri dishes (90 mm diameter and 15 mm height) under a sterile laminar flow cabinet and allowed to solidify. Media were stored in a laboratory refrigerator 4 C until the explants were placed onto the Petri dishes.
2.4. Callus Induction
Sterilized explants of three apple varieties (Braeburn, Fuji and Cripps Pink) were transferred onto MS +vits for callus induction. Five explants were placed in a petri dish and replicated five times for each variety (5 explants x 5 replicates x 3 varieties = 75 explants). The cultures were maintained in a thermostat at a temperature of 23 ± 2 °C for the first two days in the dark and then transferred to 16 h light: 8 h dark photoperiod (provided by cool-white fluorescent light) with a relative humidity level of 60 - 70 % were maintained (Perveen et al., 2012). Explants were sub-cultured when calli were induced at the edge of the explants moving small pieces of callus using a sterilised scalpel. Calli from explants was sub-divided aseptically to place on the MS + vits media. Care was taken to use fragments derived from the same region of the original callus to reduce variability. The callus medium was replaced every three weeks to subculture to achieve replicated and homogenous growth calli.
2.5. Copper Exposure to Calli Using CuSO4∙5H2O Solution
Visually homogenous callus originating from a single explant of each variety were sub-cultured three times and then used in this experiment. MS + vits media with the same hormones were used apart from concentrations of CuSO4∙5H2O. A stock solution of Cu was prepared by dissolving 3,930 mg Cu2+ sulphate pentahydrate (CuSO4∙5H2O) in 1,000 mL of deionised water (Malacas et al., 2019). 1000 ppm of CuSO4∙5H2O stock solution was used to amend Cu concentration in the MS +vits media. CuSO4∙5H2O was applied to make MS + vits media as follows: 0.006 (control, no addition), 1, 5, 10, 15 and 20 mg Cu kg-1. Five calli were placed in one media and replicated five times in each variety (5 explants x 5 replicates x 6 different CuSO4∙5H2O does x 3 varieties = 450 calli). The cultures were maintained in a thermostat at a temperature of 23 ± 2 °C the in the darkness, and a relative humidity level was maintained at 60 - 70 %. Calli’s growth was observed for 40 days.
2.6. Cu Analysis in Callus by AAS
Dried callus material was ground to powder by mortar and wet-digested in 65 % nitric-perchloric acid (1 mL per 0.1 g of dry matter). The digested material was suspended in distilled water (USEPA, 1996), and the total concentrations of Cu were determined by GBC Avanta Atomic Absorption Spectrophotometer (AAS).
2.7. Parameters’ Calculation
2.7.1. Callus Growth
Calli’s growth became lagged in 40 days. The callus size was marked in 25 days and 40 days on the back side of Petri dishes to calculate callus growth until growing stopped. Pictures were taken to check the growth of the callus visually. The ImagJ software measured the area of the callus in each sample.
Figure 1 explains net callus growth in 25 and 40 days and the calculation of total callus growth (mm2).
2.7.2. Dry Weight (g)
After measuring callus growth, 50 pieces of calli were used to determine dry weight (g). Calli were removed from the media and rinsed with DI water. Fresh calli were oven-dried (65 °C) and kept it in a desiccator for one day. The dry weight (g) was measured after one week’s dehydration.
2.7.3. Tolerance Index (TI, %)
After measuring callus growth, 50 pieces of calli were used to determine Cu resistance. Calli were removed from the media, rinsed with DI water, oven-dried at 70 °C for one week, and weighed before Cu analysis. Tolerance indices (TI) were calculated using the formula (Watmough & Dickinson, 1995):
Callust: Dried weight of callus on media with Cu concentration (1, 5, 10, 15 and 20 mg Cu kg-1); Callusc: Dried weight of callus on media without Cu addition (control, 0.006 mg Cu kg-1).
2.7.4. Bioaccumulation Factor (BCF)
The bioaccumulation factor (BCF) was used to quantify the bioaccumulation effect of calli in the uptake of Cu from media. It indicates a plant’s capacity to accumulate heavy metals (United States Environmental Protection Agency, 2005). BCF was calculated as follows:
2.8. Statistical Analysis
In this research, various statistical methods were applied to evaluate the effects of copper concentration and apple variety on physiological traits in a controlled callus-media system. The Shapiro-Wilk test was initially used to assess the normality of the data. A two-way analysis of variance (ANOVA) was conducted to examine the effects of two independent factors: media copper concentration and apple variety. The ANOVA was used to determine their individual and interactive effects on multiple dependent variables, including callus copper concentration, growth parameters (G25, G40, Gtotal), fresh weight (FW), dry weight (DW), tolerance index (TI), and the bioconcentration factor (BCF). When the two-way ANOVA identified significant differences (p < 0.05), Tukey’s Honest Significant Difference (HSD) test was applied as a post-hoc analysis. In addition, Pearson correlation analysis was performed to explore the relationships between various physiological traits and copper concentration. The statistical results were presented using line plots, which visually represented the distribution of copper accumulation, growth, fresh and dry weight, tolerance index, and bioconcentration factor across different copper concentrations and apple varieties. All statistical analyses were conducted using Python software.
3. Results
3.1. Callus Cu Accumulation
The copper concentration in the media resulted in a significant increase in callus copper accumulation across the three apple varieties (
Figure 2). Braeburn and Fuji exhibited higher copper accumulation than Cripps Pink (
Figure 3.A). When exposed to 15 mg Cu kg⁻¹, the callus copper concentration in Braeburn and Fuji ranged from 0 to 103.24 mg kg⁻¹. At the higher concentration of 20 mg Cu kg⁻¹, Braeburn reached 3150 mg kg⁻¹ and Fuji reached 4200 mg kg⁻¹. Cripps Pink showed a more gradual increase in copper accumulation, reaching 117.5 mg kg⁻¹ at 10 mg Cu kg⁻¹. At 15 mg Cu kg⁻¹, Cripps Pink’s callus copper concentration reached 1800 mg kg⁻¹, and at 20 mg Cu kg⁻¹, it slightly declined to 1700 mg kg⁻¹.
3.2. Callus Growth
Copper exposure led to a reduction in callus growth (measured by G
25, G
40, and G
total) in all three apple varieties (
Figure 2). "Braeburn’s callus growth was stimulated in the 5 mg Cu kg⁻¹ media, with a 1.43 times increase compared to the control (
Figure 3.B, C, D). However, growth was inhibited in the 15 mg Cu kg⁻¹ media, reducing to 0.27 times that of the control, and there was no growth observed at 20 mg Cu kg⁻¹. Fuji exhibited no growth at copper concentrations above 10 mg Cu kg⁻¹. In contrast, Cripps Pink maintained some degree of growth at 20 mg Cu kg⁻¹, with G
total reduced to 0.81 and 0.72 times at 5 and 20 mg Cu kg⁻¹, respectively.
3.3. Fresh Weight and Dry Weight
Fresh weight (FW) and dry weight (DW) showed similar trends across the three varieties. At lower copper concentrations (up to 5 mg Cu kg⁻¹), the callus exhibited stable or increased growth. Braeburn maintained FW values of 3.2 g at 15 mg Cu kg⁻¹, but a sharp decline was observed at 20 mg Cu kg⁻¹ (
Figure 3.E). FW reductions in Cripps Pink began at 5 mg Cu kg⁻¹ and further decreased at higher copper concentrations. Fuji displayed no growth in terms of FW or DW at copper concentrations above 10 mg Cu kg⁻¹. In terms of dry weight, Braeburn and Fuji exhibited similar reductions in DW at concentrations of 15 mg Cu kg⁻¹ and above (
Figure 3.F). Cripps Pink showed more stable DW values at lower concentrations but also exhibited a decline in DW at 20 mg Cu kg⁻¹.
3.4. Tolerance index (TI) and Bioaccumulation Factor (BCF)
The tolerance index (TI) differed across the varieties, with Fuji exhibiting a marked decrease in TI at copper concentrations above 15 mg Cu kg⁻¹ (
Figure 3.G). Cripps Pink maintained TI values above 100 % at all copper concentrations tested. Braeburn’s TI remained above 100 % at most concentrations but dropped below this level at 20 mg Cu kg⁻¹. The bioaccumulation factor (BCF) increased with higher copper concentrations for all varieties. Fuji had the highest BCF at 20 mg Cu kg⁻¹, reaching 210, while Cripps Pink peaked at 15 mg Cu kg⁻¹ with a BCF of 120 (
Figure 3.H).
3.5. Two-Way ANOVA Outcomes
The two-way ANOVA revealed significant effects of both apple variety and media Cu concentration on all dependent variables, including callus Cu concentration, G
25, G
40, G
total, fresh weight (FW), and bioconcentration factor (BCF) (p < 0.05). Additionally, the interaction between variety and media Cu concentration was statistically significant for these traits (p < 0.05). For most of the dependent variables, media Cu concentration had a stronger effect than apple variety, as evidenced by higher sum of squares (SS) and F-values for media Cu concentration compared to variety (
Table 4). However, for Translocation Index (TI), apple variety had a larger influence, with higher SS and F-values (F = 619, p < 0.05).
In the ANOVA conducted after excluding media Cu concentrations above 10 mg kg⁻¹, the influence of apple variety became more pronounced across several dependent variables, including callus Cu concentration, G25, and FW, where the SS and F-values for variety increased, while the effect of media Cu concentration diminished (
Table 4).
4. Discussion
4.1. Callus Parameters as Indicators of Copper Toxicity
Braeburn and Fuji exhibited significant copper accumulation at 20 mg Cu kg⁻¹, suggesting higher susceptibility to copper toxicity relative to Cripps Pink, which demonstrated lower copper uptake (
Figure 3.A). These results indicate varietal differences in copper transport and regulation. Fuji’s marked callus growth inhibition at concentrations above 10 mg Cu kg⁻¹ suggests greater sensitivity (
Figure 3.B,C,D), contrasting with Cripps Pink's more gradual response, indicating potential tolerance mechanisms (Yruela, 2009)."
The Tolerance Index (TI) values highlighted varietal differences in copper sensitivity (
Figure 3.G). Fuji’s sharp decrease in TI at 15 mg Cu kg⁻¹ reinforced its vulnerability, while Cripps Pink’s consistent TI above 100% across all concentrations indicated a higher degree of tolerance. This could be attributed to enhanced copper sequestration or antioxidant defenses (Usman et al., 2012).
The Bioaccumulation Factor (BCF) also revealed Fuji’s higher copper translocation at 20 mg Cu kg⁻¹, while Cripps Pink exhibited lower BCF despite high copper exposure (
Figure 3.H). This suggests that Cripps Pink may employ mechanisms to limit copper’s toxic effects, such as vacuolar sequestration, which aligns with findings in other metal-tolerant species (De Marco et al., 2016).
4.2. Biomass Reduction and Sensitivity Thresholds
The reduction in fresh weight (FW) and dry weight (DW) at copper concentrations above 10 mg Cu kg⁻¹ highlights the onset of significant copper stress, with Braeburn showing slightly better resilience at 15 mg Cu kg⁻¹ compared to Fuji (
Figure 3.E,F). This suggests that varietal differences in tolerance thresholds exist, but are overwhelmed at higher copper levels (Tamta et al., 2021). The observed biomass reduction supports the identification of 10 mg Cu kg⁻¹ as a critical threshold for copper toxicity. Beyond this point, the physiological stress is sufficient to override varietal differences, leading to uniform reductions in growth and biomass, consistent with copper stress studies in other plant species (Javed et al., 2017).
4.3. High Copper Concentrations Override Varietal Differences
The two-way ANOVA results illustrated that high copper concentrations ( > 10 mf kg
-1) overridden the inherent genetic variability of the apple varieties (
Table 4, left column). Under these conditions, copper stress induced a uniform physiological response that diminished the role of genetic diversity. This pattern aligned with previous findings, which showed that heavy metal stress can suppress genetic variability by imposing a dominant stress response across genotypes (Yruela, 2009; Tamta et al., 2021). In this study, traits like callus Cu concentration and BCF were more strongly influenced by the copper concentration in the media, reflecting the overriding effect of copper stress.
However, when media Cu concentrations above 10 mg kg⁻¹ were excluded from the analysis (
Table 4, right column), the influence of apple variety became more pronounced. The increase in SS and F-values for variety indicated that under moderate copper conditions, the genetic differences between the apple varieties played a more significant role in determining callus Cu concentration, G
25, and FW. This suggests that high copper levels can negate genetic advantages related to stress tolerance, leading to a convergence of physiological responses under extreme copper stress (Javed et al., 2017). Interestingly, for Translocation Index (TI), the genetic differences between apple varieties remained important even at lower copper concentrations, as evidenced by the larger SS and F-values for variety. This suggests that copper translocation within the plant tissues is more tightly regulated by genetic factors, regardless of the external copper stress.
4.4. Extrapolation to Soil-Plant Systems
The callus experiment provided valuable insights into how copper stress may affect whole plants in soil-plant systems. Although the in vitro conditions used in this study differ from natural soil environments, where buffering mechanisms such as organic matter and microbial activity can mitigate the effects of copper toxicity, the results suggest that media copper concentrations above 10 mg Cu kg⁻¹ may pose a risk to plant health. The masking effect observed in callus systems, where copper toxicity overrides varietal differences, may also occur in soil environments, particularly in soils with low organic matter or poor buffering capacity. In such soils, the high copper concentrations could lead to impaired root growth, reduced water and nutrient uptake, and overall decreased plant vigor, as seen in the callus experiment. These findings were consistent with studies that have reported similar copper toxicity effects in soil-grown plants, where high soil copper levels led to reductions in plant growth, chlorosis, and stunted development (De Marco et al., 2016).
Additionally, soil microbial activity could be negatively affected by elevated copper concentrations, further compounding the negative effects of copper on plant growth. Copper toxicity in soils can inhibit beneficial microbial processes, such as nutrient cycling and nitrogen fixation, leading to poorer soil health and reduced plant productivity. The bioaccumulation factor (BCF) observed in the callus experiment, particularly at high copper concentrations, suggests that in a soil-plant system, similar translocation of copper into plant tissues could occur, potentially leading to toxic levels of copper in plant biomass. This aligns with findings from in vivo studies that have shown copper accumulation in plant tissues to be a major concern in soils with high copper content (Usman et al., 2012).
4.5. Implications for Agricultural Practices and Soil Health
The results of this study highlight the importance of managing copper concentrations in agricultural soils to avoid copper toxicity and preserve varietal performance. As demonstrated by the callus experiment, copper concentrations above 10 mg Cu kg⁻¹ result in significant growth inhibition and biomass reduction, particularly in more sensitive varieties such as Fuji. Maintaining copper levels below this threshold in soils is crucial to ensure that apple varieties can express their full genetic potential and maintain healthy growth.
The observed differences in copper tolerance between the apple varieties suggest that careful varietal selection should be considered in areas where soil copper concentrations are elevated. For instance, Cripps Pink's higher tolerance to copper suggests that this variety may be better suited for cultivation in copper-affected soils, while Fuji, with its higher sensitivity, may require stricter copper management practices. Furthermore, integrating organic amendments and improving soil organic matter content could help mitigate copper toxicity by enhancing the soil's buffering capacity and promoting beneficial microbial activity (Sarkar et al., 2010).
4.6. Limitations And Future Research Directions
While the callus-media system provides a controlled environment for studying copper toxicity, it is important to acknowledge its limitations in fully replicating soil-plant systems. In vitro conditions lack the complex interactions found in natural soils, such as root-microbe interactions, organic matter influences, and the dynamic water and nutrient cycles. As a result, the extrapolation of these findings to field conditions should be approached with caution. Future research should focus on conducting in vivo experiments in soil-plant systems to validate the findings of this study and explore the effects of copper toxicity in more realistic agricultural settings. Additionally, further research is needed to investigate the long-term effects of copper toxicity on apple varieties in soil, including potential adaptations and tolerance mechanisms that may develop over time.
5. Conclusions
This study demonstrated that high copper concentrations significantly affect key physiological traits, including callus growth, copper accumulation, fresh and dry weight, and bioconcentration factor (BCF). The two-way ANOVA revealed that media Cu concentration had a dominant influence over varietal differences, particularly at concentrations above 10 mg kg⁻¹, where copper stress overrode the genetic variability between apple varieties. Under extreme copper stress, the physiological response became more uniform across varieties, with high copper levels suppressing the expression of genetic potential. In contrast, at moderate copper concentrations, the influence of genetic differences became more prominent. This indicates that lower copper levels allow varietal traits to play a more significant role in determining apple callus performance. Notably, Cripps Pink variety exhibited greater copper tolerance compared to Braeburn and Fuji varieties, suggesting its potential suitability for cultivation in environments with elevated copper exposure. Although this study was conducted in a controlled callus-media system, the findings provide valuable insights into how copper stress may impact apple varieties in real-world soil-plant systems. The callus-media system proved to be a reliable model for investigating copper toxicity, and the results suggest that maintaining copper levels below critical thresholds is essential for preserving varietal differences and optimizing apple performance. Future research should aim to validate these findings in soil-plant systems to further refine copper management practices in apple orchards.
Funding
This research received no external funding.
Institutional Review Board Statement
Not applicable.
Informed Consent Statement
Not applicable.
References
- United Fresh New Zealand Incorporated. Fresh Facts: New Zealand Horticulture 2020. Freshfacts 2020. https://www.freshfacts.co.nz/files/freshfacts-2020.pdf.
- Girotto, E.; Ceretta, C. A.; Brunetto, G.; Miotto, A.; Tiecher, T. L.; De Conti, L.; Lourenzi, C. R.; Lorensini, F.; Gubiani, P. I.; da Silva, L. S.; Nicoloso, F. T. Copper availability assessment of Cu-contaminated vineyard soils using black oat cultivation and chemical extractants. Environ. Monit. Assess. 2014, 186(12), 9051–9063. [CrossRef]
- Komárek, M.; Čadková, E.; Chrastný, V.; Bordas, F.; Bollinger, J. C. Contamination of vineyard soils with fungicides: A review of environmental and toxicological aspects. Environ. Int. 2010, 36(1), 138-151. [CrossRef]
- Liu, C. S.; Sun, B. Y.; Kan, S. H.; Zhang, Y. Z.; Deng, S. H.; Yang, G. Copper toxicity and accumulation in potted seedlings of three apple rootstock species: Implications for safe fruit production on copper-polluted soils. Journal of Plant Nutrition 2011, 34(9), 1268–1277. [CrossRef]
- Li, W.; Zhang, M.; Shu, H. Distribution and Fractionation of Copper in Soils of Apple Orchards. Environ Sci & Pollut Res 2005, 12(3), 168–172. [CrossRef]
- Michigan State University. https://www.canr.msu.edu/news/an_early_season_copper_application_will_help_avoid_feeling_the_blue s_about (accessed on 20 September 2023).
- Vanneste, J. L. Fire Blight. The Disease and Its Causative Agent, Erwinia Amylovora: Migration of Erwinia amylovora in Host Plant Tissues, CABI Pub 2000, 73-81. https://www.cabidigitallibrary.org/doi/pdf/10.5555/20001008052.
- Norelli, J. L.; Jones, A. L.; Aldwinckle, H. S. Fire Blight Management in the Twenty-first Century Using New Technologies that Enhance Host Resistance in Apple. In Plant Disease 2003, 87(7).
- Bouazizi, H.; Jouili, H.; Geitmann, A.; El Ferjani, E. Copper toxicity in expanding leaves of Phaseolus vulgaris L.: Antioxidant enzyme response and nutrient element uptake. Ecotoxi. Environ. Safety 2010, 73(6), 1304–1308. [CrossRef]
- Brunetto, G.; Bastos de Melo, G. W.; Terzano, R.; Del Buono, D.; Astolfi, S.; Tomasi, N.; Pii, Y.; Mimmo, T.; Cesco, S. Copper accumulation in vineyard soils: Rhizosphere processes and agronomic practices to limit its toxicity. Chemo. 2016, 162, 293–307. [CrossRef]
- Cambrollé, J.; García, J. L.; Figueroa, M. E.; Cantos, M. Evaluating wild grapevine tolerance to copper toxicity. Chemo. 2015, 120,171-178. [CrossRef]
- Chatterjee, J.; Chatterjee, C. Phytotoxicity of cobalt, chromium and copper in cauliflower. Environ. Pollut. 2000, 109(1), 69–74. [CrossRef]
- Chen, J.; Liu, Y. Q.; Yan, X. W.; Wei, G. H.; Zhang, J. H.; Fang, L. C. Rhizobium inoculation enhances copper tolerance by affecting copper uptake and regulating the ascorbate-glutathione cycle and phytochelatin biosynthesis-related gene expression in Medicago sativa seedlings. Ecotoxi. Environ. Safety 2018, 162(March), 312–323. [CrossRef]
- Hippler, F. W. R.; Cipriano, D. O.; Boaretto, R. M.; Quaggio, J. A.; Gaziola, S. A.; Azevedo, R. A.; Mattos-Jr., D. Citrus rootstocks regulate the nutritional status and antioxidant system of trees under copper stress. Environ. Experimen. Botany 2016, 130, 42–52. [CrossRef]
- Wang, Q.; Liu, J.; Wang, Y.; Yu, H. Accumulations of copper in apple orchard soils: distribution and availability in soil aggregate fractions. J. Soil Sedi. 2015, 15(5), 1075–1082. [CrossRef]
- Cao, Y.; Zhang, Y.; Ma, C.; Li, H.; Zhang, J.; Chen, G. Growth, physiological responses, and copper accumulation in seven willow species exposed to Cu—a hydroponic experiment. Environ. Sci. Pollut. Res. 2018, 25(20), 19875–19886. [CrossRef]
- Lange, B.; Delhaye, G.; Boisson, S.; Verbruggen, N.; Meerts, P.; Faucon, M. P. Variation in copper and cobalt tolerance and accumulation among six populations of the facultative metallophyte Anisopappus chinensis (Asteraceae). Environ. Experimen. Botany 2018, 153(October 2017), 1–9. [CrossRef]
- Marastoni, L.; Sandri, M.; Pii, Y.; Valentinuzzi, F.; Brunetto, G.; Cesco, S.; Mimmo, T. Synergism and antagonisms between nutrients induced by copper toxicity in grapevine rootstocks: Monocropping vs. intercropping. Chemo. 2019, 214, 563–578. [CrossRef]
- Wan, H.; Du, J.; He, J.; Lyu, D.; Li, H. Copper accumulation, subcellular partitioning and physiological and molecular responses in relation to different copper tolerance in apple rootstocks. Tree Physio. 2019, 39(7), 1215–1234. [CrossRef]
- Imeri, R.; Kullaj, E.; Duhani, E.; Millaku, L. Impact of rootstock on heavy metal bioaccumulation in apple plant grown near an industrial source in Obiliq, Kosovo. Agro. Res. 2019, 17(1), 100–110. [CrossRef]
- Errabii, T.; Gandonou, C. B.; Essalmani, H.; Abrini, J.; Idaomar, M.; Skali Senhaji, N. Effects of NaCl and mannitol induced stress on sugarcane (Saccharum sp.) callus cultures. Acta Phys. Plant. 2007, 29(2), 95–102. [CrossRef]
- Skoog, F.; Miller, C. O. Chemical regulation of growth and organ formation in plant tissues cultured in vitro. Sympo. S. Experiment. Bio. 1957, 11, 118–131. https://pubmed.ncbi.nlm.nih.gov/13486467/.
- Fehér, A. Callus, dedifferentiation, totipotency, somatic embryogenesis: What these terms mean in the era of molecular plant biology? Front. Plant Sci. 2019, 10(April), 1–11. [CrossRef]
- Gladkov, E. A. Cell selection to increase lawn grass resistance to lead pollution. Environ. Sci. Pollut. R. 2023, 30, 24771–24778. [CrossRef]
- Gori, P.; Schiff, S.; Santandrea, G.; Bennici, A. Response of in vitro cultures of Nicotiana tabacum L. to copper stress and selection of plants from Cu-tolerant callus. Plant Cell Tiss. Organ. Cult. 1998, 53, 161–169. [CrossRef]
- Murashige, T.; Skoog, F. A. Revised Medium for Rapid Growth and Bio Assays with Tobacco Tissue Cultures. Physio. Plant. 1962, 15(3), 473–497. [CrossRef]
- Perveen, S.; Anis, M.; Aref, I. M. In vitro morphogenic response and metal accumulation in Albizia lebbeck (L.) cultures grown under metal stress. Euro. J. Forest Res. 2012, 131(3), 669–681. [CrossRef]
- Malacas, M.; Balberan, M. C.; Amal, N.; Bederi, J.; Ramos, C. J.; Rato, M.; Salazar, G.; Roque, E. The removal of copper (II) and lead (II) from aqueous solution using Fuller’s earth and Fuller’s earth-immobilized nanoscale zero valent iron (FE-NZVI ) by adsorption. MATEC Web Con. 2019, 268, 05006. [CrossRef]
- United States Environmental Protection Agency. Method 3050B: Acid Digestion of Sediments, Sludges, and Soils, 1996, (Issue Revision 2). https://www.epa.gov/sites/default/files/2015-06/documents/epa-3050b.pdf.
- United States Environmental Protection Agency. Human health risk assessment protocol for hazardous waste combustion facilities. 2005, EPA530-R-05-006. https://epa- prgs.ornl.gov/radionuclides/2005_HHRAP.pdf.
- Yruela, I. Copper in plants: Acquisition, transport and interactions. Func. Plant Bio. 2009, 36(5), 409–430. [CrossRef]
- Usman, K.; Al Ghouti, M. A.; Abu Dieyeh, M. H. The assessment of cadmium, chromium, copper, and nickel tolerance and bioaccumulation by shrub plant Tetraena qataranse. Sci. Reports 2019, 9(1). [CrossRef]
- De Marco, R.; Da Silva, R. F.; Andreazza, R.; Da Ros, C. O.; Scheid, D. L.; Bertollo, G. M. Copper Phytoaccumulation and Tolerance by Seedlings of Native Brazilian Trees. Environ. Engin. Sci. 2016, 33(3), 176–184. [CrossRef]
- Tamta, S.; Kumar, A.; Kumar, R.; Shankhdhar, D. Influence of zinc and copper on morphological characters for improving herbage yield of vegetatively propagated Bacopa monnieri (L.). Pharma. Inno. J. 2021, 10(11). http://www.thepharmajournal.com.
- Javed, S. B.; Alatar, A. A.; Basahi, R.; Anis, M.; Faisal, M.; Husain, F. M. Copper induced suppression of systemic microbial contamination in Erythrina variegata L. during in vitro culture. Plant Cell Tiss. Organ. Cult. 2017, 128, 249–258. [CrossRef]
- Sarkar, T.; Vijay Anand, K. G.; Reddy, M. P. Effect of nickel on regeneration in Jatropha curcas L. and assessment of genotoxicity using RAPD markers. BioMetals 2010, 23(6), 1149–1158. [CrossRef]
|
Disclaimer/Publisher’s Note: The statements, opinions and data contained in all publications are solely those of the individual author(s) and contributor(s) and not of MDPI and/or the editor(s). MDPI and/or the editor(s) disclaim responsibility for any injury to people or property resulting from any ideas, methods, instructions or products referred to in the content. |
© 2024 by the authors. Licensee MDPI, Basel, Switzerland. This article is an open access article distributed under the terms and conditions of the Creative Commons Attribution (CC BY) license (http://creativecommons.org/licenses/by/4.0/).